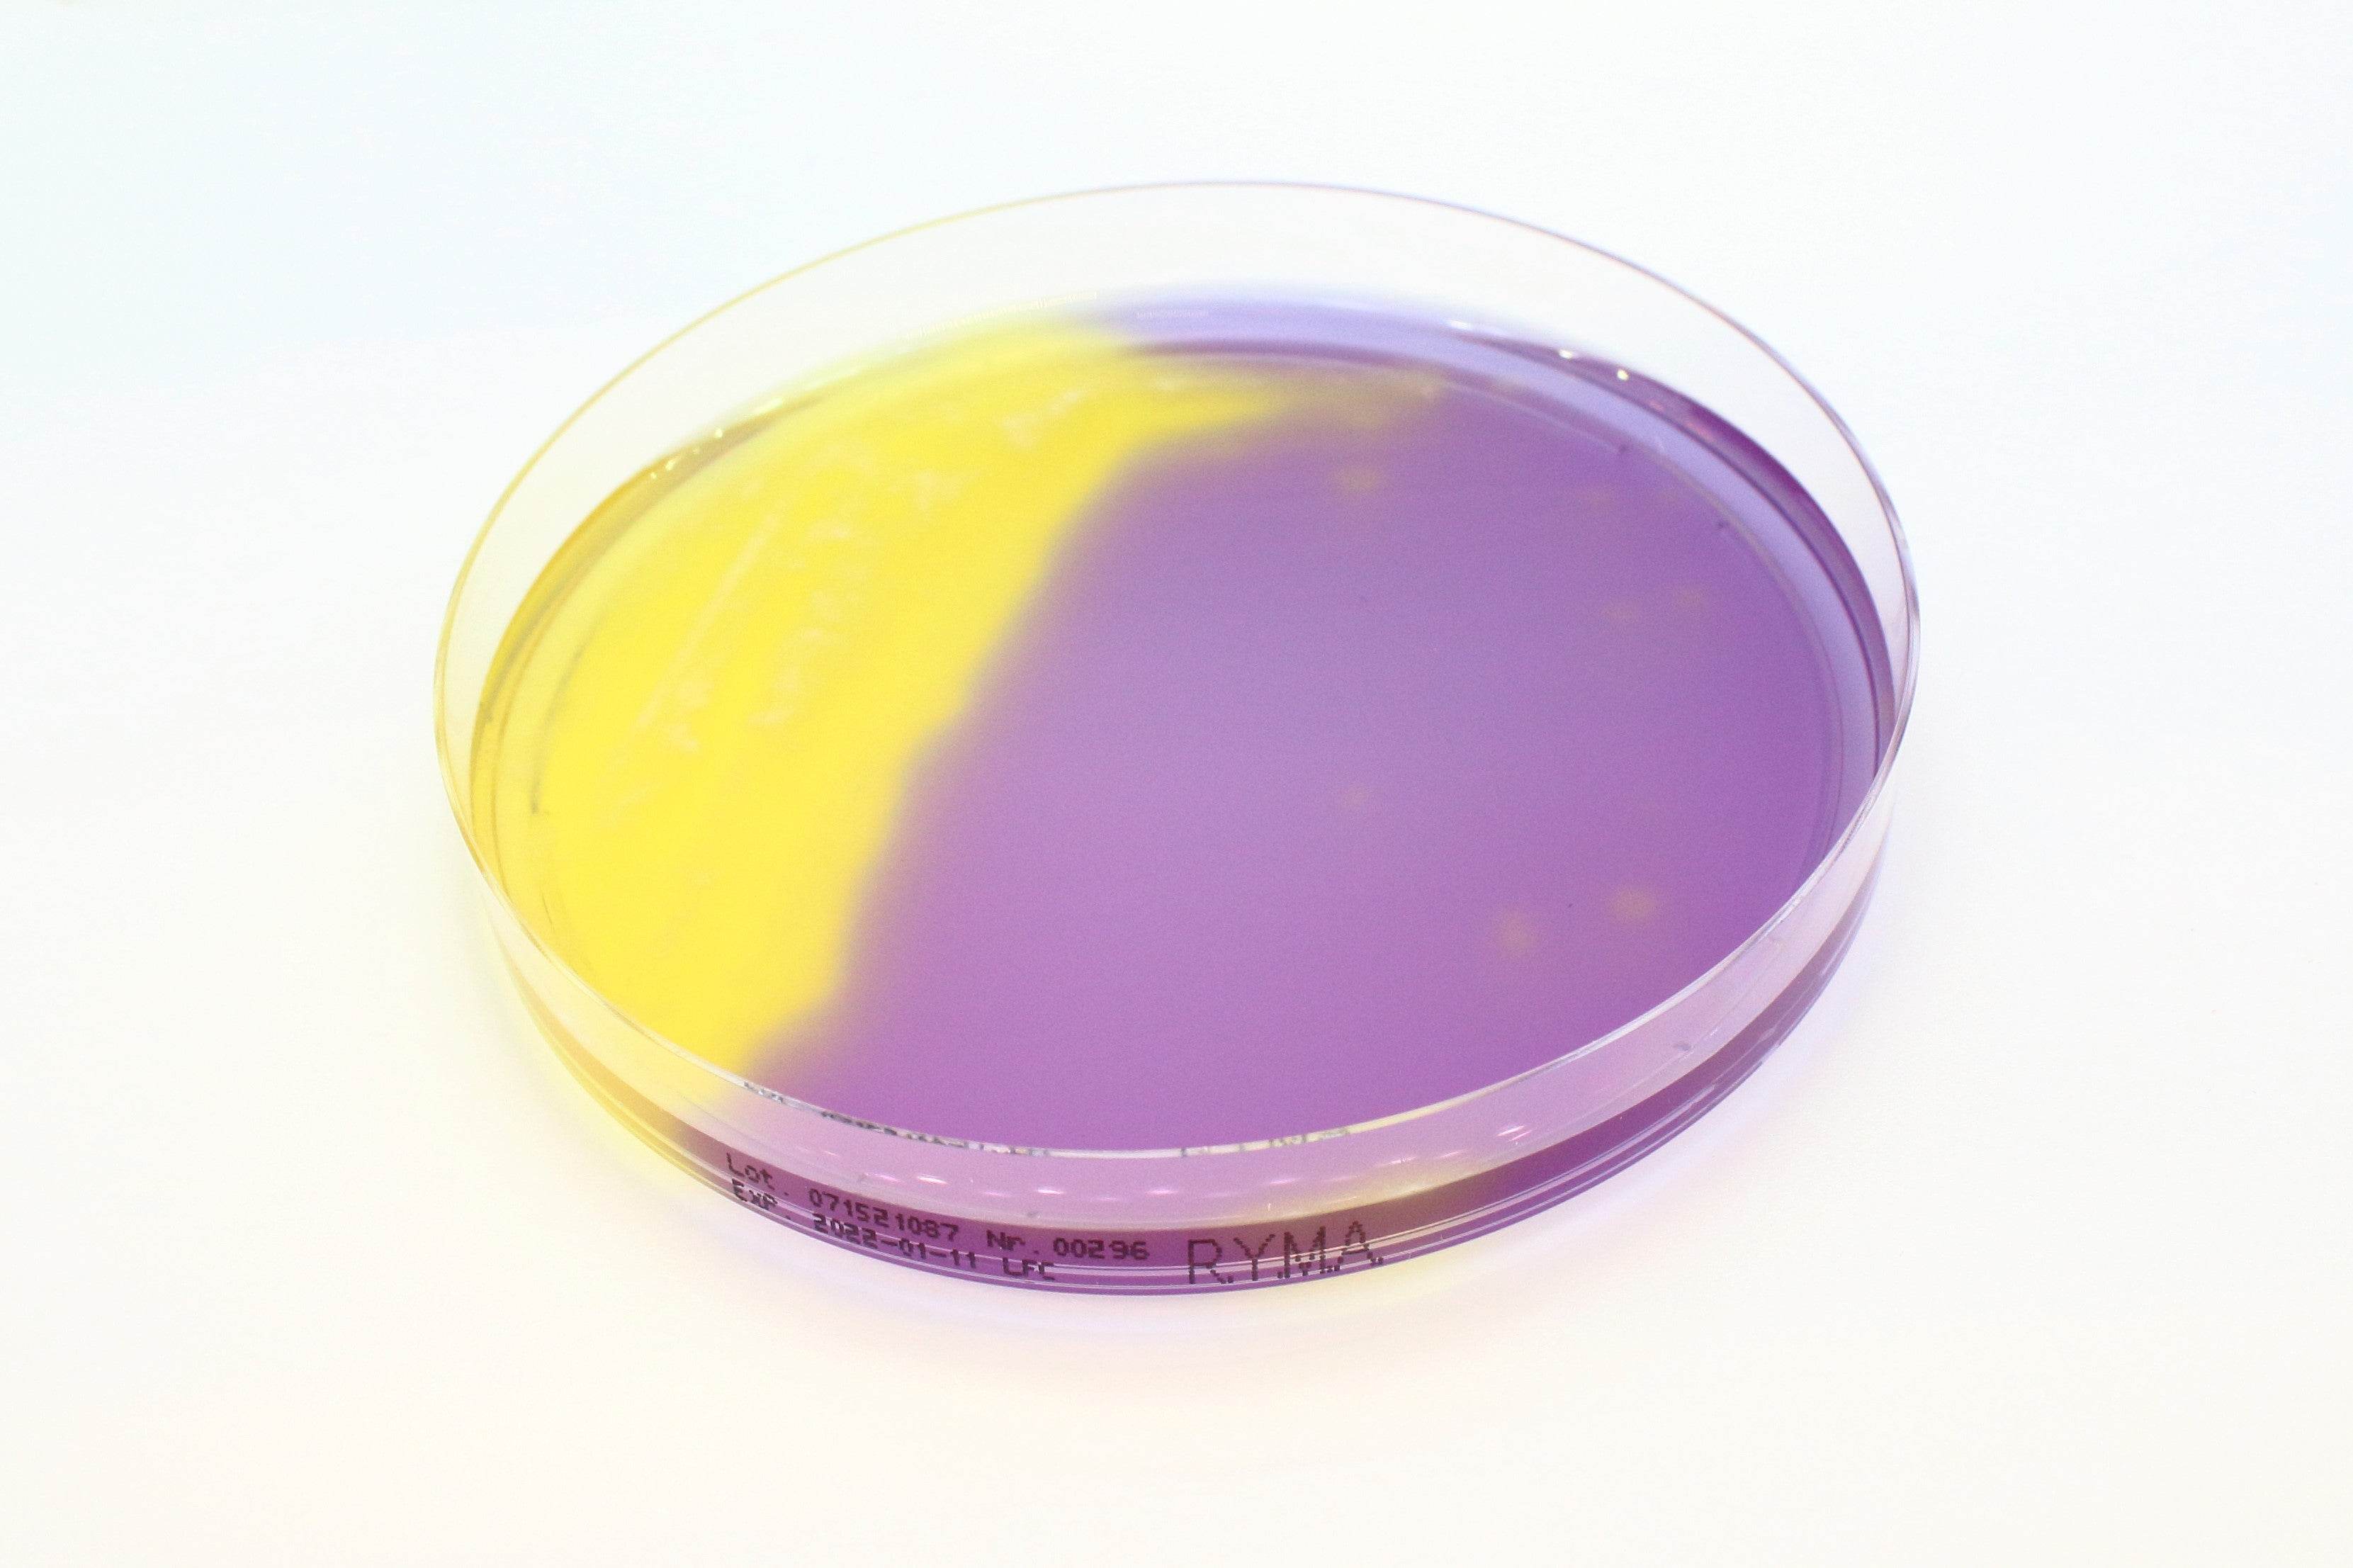
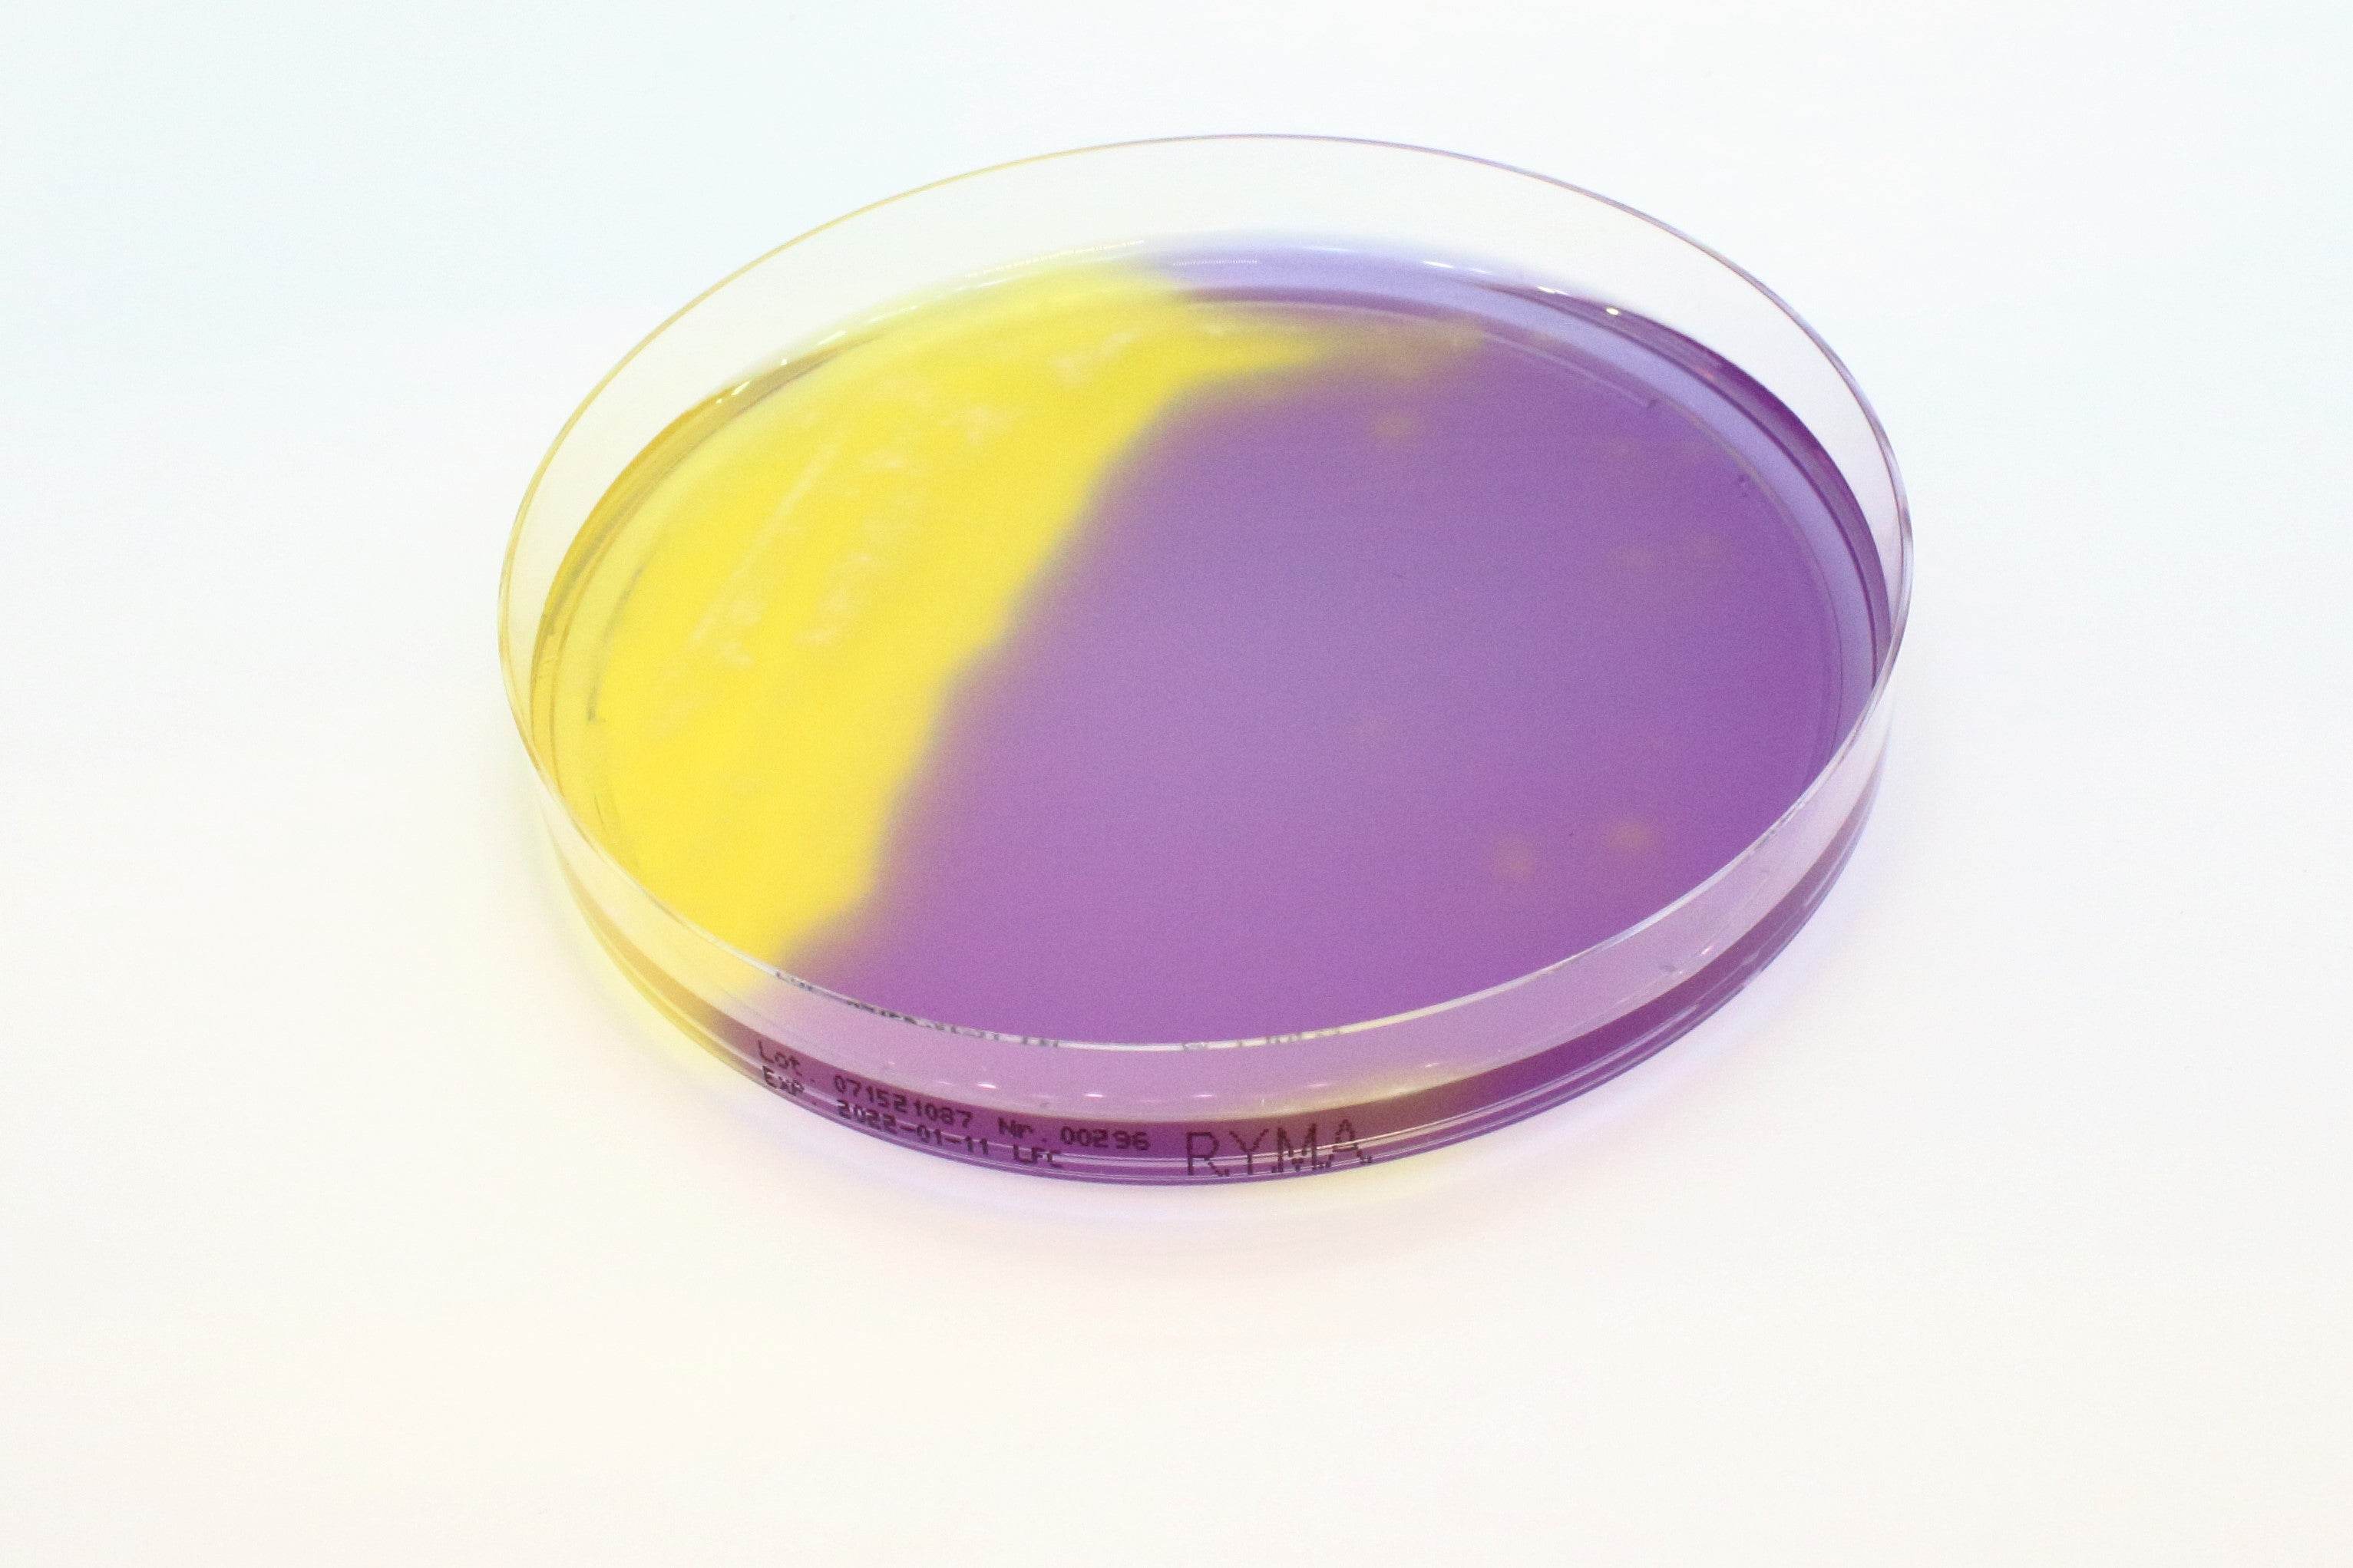

All Products
Showing 1393 - 1416 of 1448 products
Display
View


Liofilchem
Sabouraud Dextrose Broth (screw cap) - For Microbiology Lab Testing
Sale priceFrom $68.00 CAD
![AF GENITAL SYSTEM Reagent [Unit = 100 Tests] - Kormay Biomedicals store](http://www.kormay.ca/cdn/shop/files/80258AFGenitalSystemReagents_6.jpg?v=1757108070&width=1620)
![AF GENITAL SYSTEM Reagent [Unit = 100 Tests] - Kormay Biomedicals store](http://www.kormay.ca/cdn/shop/files/80258AFGenitalSystemReagent_1.jpg?v=1757108070&width=3061)
Liofilchem
AF GENITAL SYSTEM Reagent [Unit = 100 Tests] - For Microbiology Lab Testing
Sale price$195.00 CAD

Liofilchem
Alkaline Saline Peptone Water ISO - For Microbiology Lab Testing
Sale priceFrom $215.00 CAD

Liofilchem
Tryptic Soy Agar + Lactamator 1000 IU (Irradiated) - For Microbiology Lab Testing
Sale price$269.00 CAD


Liofilchem
Tryptic Soy Broth + 1% Tween 80 - For Microbiology Lab Testing
Sale priceFrom $101.00 CAD
Filters (0)